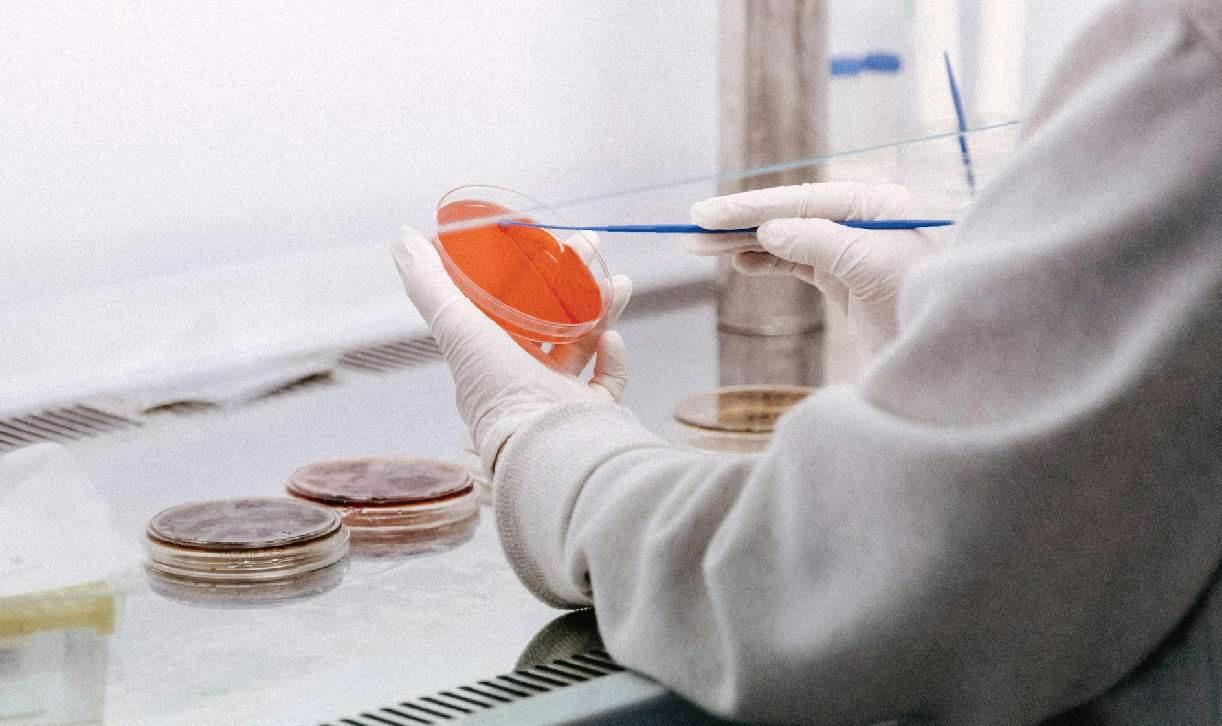

派斯德愿景
派斯德公司以預防勝于治療為產品研發理念,從體內到體外守護動物健康,
透過內外兼顧的方式來減少抗生素使用,將守護動物及食品安全作為我們的首要目標。
走進派斯德
上海派斯德生化有限公司于1993年成立,主要從事消毒劑、功能性營養添加劑的研發、生產與技術服務。

所有產品
派斯德公司以預防勝于治療為產品研發理念,從體內到體外守護動物健康。
實務案例
派斯德秉持「腳踏實地、追根究底、實事求是、務實經營、積極創新」之企業精神,為造福廣大的人群,派斯德公司將不斷努力,研發更好的產品。


派斯德學院
樹立重視健康科學養殖的理念,實現行業科學發展。派斯德積極體驗時代發展變化,以務實心態幫助大家成長為優秀的禽畜業專業人才。








